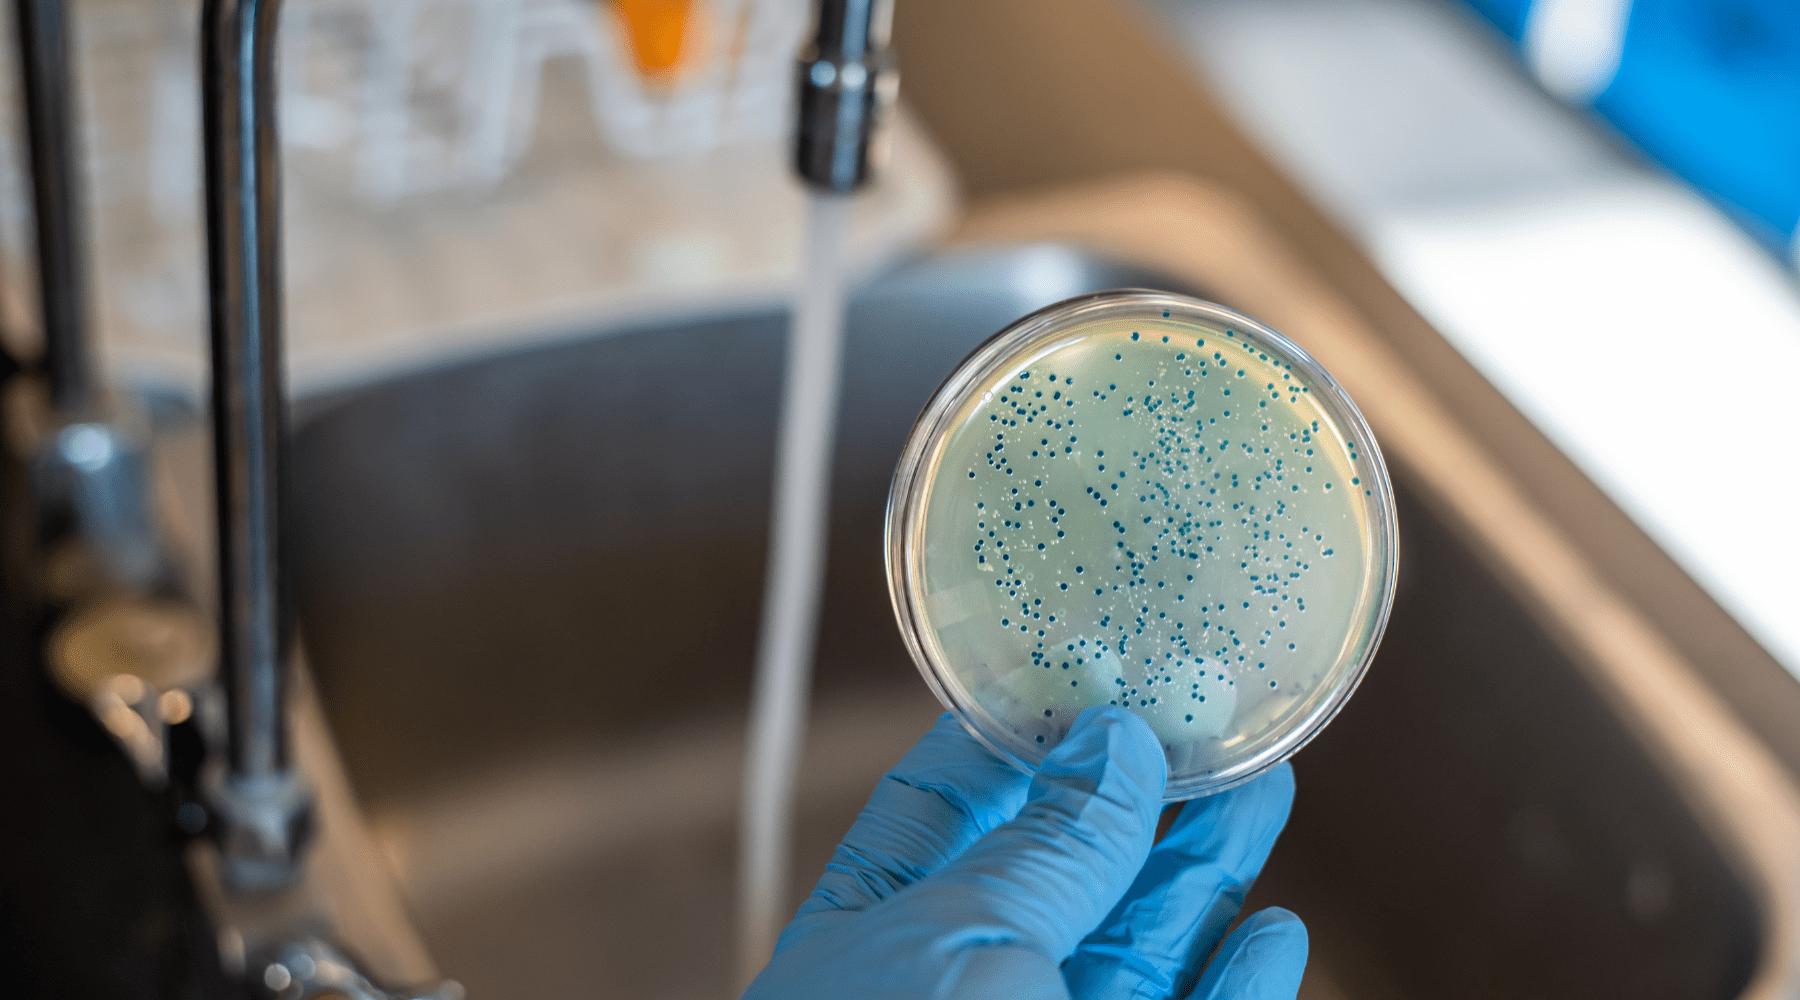

Osmose im Kriseneinsatz: Sauberes Trinkwasser in Notfallsituationen
Einleitung
Wasser ist die wichtigste Ressource für das Überleben, insbesondere in Krisensituationen. Naturkatastrophen, Kriege und andere Notfälle können dazu führen, dass Menschen plötzlich keinen Zugang zu sauberem Trinkwasser mehr haben. Osmoseanlagen sind dabei eine unverzichtbare Technologie, um auch unter extremen Bedingungen sicheres Trinkwasser zu gewinnen. Osmose-Technologie gegen Keime, Viren und Bakterien bietet eine zuverlässige Lösung, um Wasser aus Flüssen, Seen oder kontaminierten Quellen in lebensrettendes Trinkwasser zu verwandeln. In diesem Beitrag erfährst du, warum Osmose-Technologie für den Kriseneinsatz unverzichtbar ist und wie sie den Zugang zu sicherem Wasser in schwierigen Zeiten sichert.
Warum ist Wasser in Krisengebieten ein Problem?
In Krisengebieten – sei es durch Naturkatastrophen, militärische Konflikte oder den Zusammenbruch der Infrastruktur – ist der Zugang zu sauberem Trinkwasser stark eingeschränkt. Wasserquellen sind häufig durch Bakterien, Viren oder Chemikalien verunreinigt, was in vielen Fällen zu schweren Krankheiten führt. Gerade in Krisengebieten wie Flüchtlingslagern, Kriegsgebieten oder nach Naturkatastrophen ist die Gefahr von Wasser-Übertragbaren Krankheiten wie Cholera oder Typhus besonders hoch.
Wie funktioniert eine Osmoseanlage im Kriseneinsatz?
Die Osmose-Technologie nutzt das Prinzip der Umkehrosmose, bei dem Wasser unter Druck durch eine halbdurchlässige Membran gepresst wird. Diese Membran entfernt fast alle Verunreinigungen, Bakterien, Viren und Schadstoffe. Der Prozess funktioniert folgendermaßen:
- Vorfilterung: Entfernt grobe Schwebstoffe und Partikel wie Sand und Sedimente.
- Aktivkohlefilter: Reduziert Chemikalien, Chlor und Gerüche aus dem Wasser.
- Osmosemembran: Filtert bis zu 99,99 % aller Verunreinigungen, einschließlich Bakterien und Viren.
- Nachfilter: Optimiert Geschmack und entfernt letzte Reststoffe.
Vorteile der Osmose-Technologie in Krisensituationen
- Osmoseanlagen ermöglichen die Nutzung von Fluss-, See- oder verschmutztem Wasser, das normalerweise nicht trinkbar wäre.
- Die Technologie entfernt zuverlässig Schadstoffe, Krankheitserreger und chemische Verunreinigungen.
- Mobile Systeme ermöglichen eine autarke Wasseraufbereitung ohne Stromanschluss, ideal für den Kriseneinsatz und humanitäre Hilfe.
- Leicht zu transportieren und einfach zu bedienen – ideal für den Einsatz durch Militärs, das Rote Kreuz oder in Flüchtlingslagern.
Osmose im Einsatz: Militär, Rotes Kreuz und Notfallmedizin
In vielen Krisenregionen weltweit spielt Osmose-Technologie eine entscheidende Rolle. Hier sind einige wichtige Einsatzszenarien:
Militärische Anwendungen
Das Militär benötigt zuverlässige Systeme, um in abgelegenen Gebieten oder bei Einsätzen ohne stabile Infrastruktur sauberes Trinkwasser zu gewinnen. Mobile Osmoseanlagen werden in Krisenregionen, bei Militärübungen oder in bewaffneten Konflikten eingesetzt. Sie ermöglichen den Soldaten, auf kontaminierte Wasserquellen zurückzugreifen und diese in sicheres Trinkwasser zu verwandeln.
Rotes Kreuz und humanitäre Hilfe
Humanitäre Organisationen wie das Rote Kreuz setzen Osmoseanlagen weltweit ein, um in Flüchtlingslagern und bei Katastrophenhilfe für Millionen von Menschen zu sorgen. Diese Anlagen bieten notleidenden Menschen sauberes Wasser und helfen, die Ausbreitung von wasserbedingten Krankheiten zu verhindern.
Gesundheitsversorgung in Krisenregionen
Krankenhäuser und Lazarette in Krisengebieten sind auf sauberes Wasser angewiesen, um Infektionen zu verhindern und die medizinische Versorgung sicherzustellen. Hier kommt die Osmose-Technologie zum Tragen, um Wasser zur Desinfektion, für medizinische Zwecke und zur Versorgung von Patienten zur Verfügung zu stellen. Besonders für Schwangere, Kinder und Kranke ist der Zugang zu sauberem Wasser entscheidend für die Erholung und die Verhinderung von Infektionen.
Für Schwangere und Kinder
Schwangere Frauen und Kinder sind besonders anfällig für die negativen Auswirkungen von verunreinigtem Wasser. Osmoseanlagen bieten in Krisensituationen eine zuverlässige Lösung, um sicherzustellen, dass auch die vulnerabelsten Bevölkerungsgruppen mit sauberem Wasser versorgt werden.
Jetzt für Krisensituationen vorsorgen!
Sichere dir eine mobile Osmoseanlage und stelle sicher, dass du in jeder Situation Zugang zu sauberem Wasser hast. Jetzt informieren!